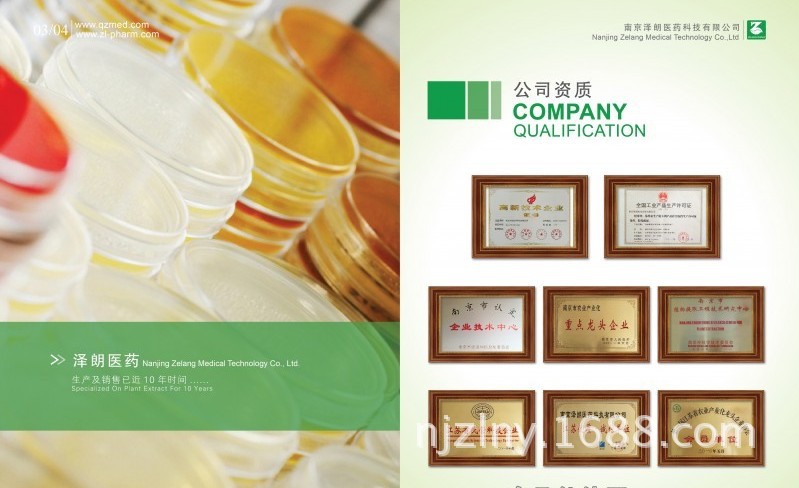
荣誉资质

植物来源:伞形科植物川芎的干燥根
别 名:四甲基吡嗪
分子式:C8H13CIN2
分子量:172.65
CAS号:76494-51-4
检测方式:高效液相色谱法
规格:≥98%
性状:白色结晶性粉末;气微,味辛。
产品作用:
具有抗血小板聚集、扩张小动脉、改善微循环和脑血流的作用。用于闭塞性血管疾病、脑血栓形成、脉管炎、冠心病、心绞痛等。
公司特色优势:
1、国内对植提,对照品行业领导者,长达十余年的产品开发与研究。
2、提供产品代加工服务。
3、提供商检等出口事宜。
4、高效稳定的专业纯化技术。
5、严格的质量控制,通过全面的检测(HPLC、13CNMR)
6、完善的库存及供应体系。
7、高效的销售团队。
8、ISO9000质量管理体系认证。

登录后方可查看联系方式
